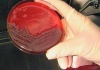
Споры сибирской язвы обнаружены в Курской области

Новости отрасли
|
Производители из Китая - главные конкуренты тульских кролиководов 22.05.2013 |
|
Споры сибирской язвы обнаружены в Курской области 22.05.2013 |
|
Мясопереработчики всего мира могут отказаться от глутамата натрия 22.05.2013 |
|
Медведев: Сельское хозяйство должно получать более мощную господдержку 22.05.2013 |
|
|
В Курганской области проходит смотр организации перевода скота на летне-пастбищное содержание 22.05.2013 |
|
Исконно русский продукт в новом качестве от «Атяшево» 22.05.2013 |
|
25 тонн свинины из Польши приостановили сотрудники Колымского Россельхознадзора на государственной границе 22.05.2013 |
|
Канадская элита переселяется на Южный Урал. В регион везут породистых свиноматок 22.05.2013 |
|
Ростовстат отчитался о работе сельскохозяйственных кооперативов 22.05.2013 |
|
Ставропольские овцеводы взяли главный приз главы Калмыкии 22.05.2013 |